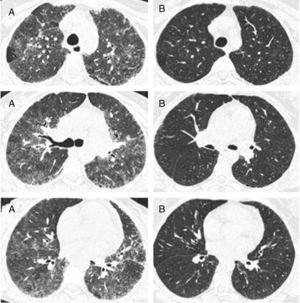
Representative images of HRCT scan after and before treatment with prednisone and DMARDs. (A) Basal HRCT images, showing bilateral ground-glass images, centroliobular nodules and lobular areas of decreased attenuation. (B) There is a general improvement of the ground glass and no images of centroliobular nodules and lobular areas of decreased attenuation. The patient was treated with prednisone, methotrexate and sulphasalazine. There is a difference of 16 months between basal HRCT (A) and follow-up HRCT (B).

To describe the association between rheumatoid arthritis disease activity (RA) and interstitial lung damage (inflammation and fibrosis), in a group of patients with rheumatoid arthritis-associated interstitial lung disease (RA-ILD).
MethodsA retrospective study of RA patients with interstitial lung disease (restrictive pattern in lung function tests and evidence of interstitial lung disease in high resolution computed tomography (HRCT)). Patients were evaluated to exclude other causes of pulmonary disease. RA disease activity was measured with the CDAI index. Interstitial lung inflammation and fibrosis were determined by Kazerooni scale. We compared Kazerooni ground-glass score with the nearest CDAI score to HRCT date scan of the first medical evaluation at our institution. In nine patients, we compared the first ground-glass score with a second one after treatment with DMARDs and corticosteroids. Spearman's rank correlation coefficient was used to evaluate association between RA disease activity and the Kazerooni ground-glass and fibrosis scores.
ResultsThirty-four patients were included. A positive correlation between CDAI and ground-glass scores was found (rs=0.3767, P<0.028). Fibrosis and CDAI scores were not associated (rs=−0.0747, P<0.6745). After treatment, a downward tendency in the ground-glass score was observed (median [IQR]): (2.33 [2,3] vs. 2 [1.33–2.16]), P<0.056, along with a lesser CDAI score (27 [8–43] vs. 9 [5–12]), P<0.063.
ConclusionThere is a correlation between RA disease activity and ground-glass appearance in the HRCT of RA-ILD patients. These results suggest a positive association between RA disease activity and lung inflammation in RA-ILD.
Describir la asociación entre la actividad de la artritis reumatoide (AR) y la afectación intersticial pulmonar (inflamación y fibrosis), en un grupo de pacientes con enfermedad pulmonar intersticial asociada a la artritis reumatoide.
MétodosEstudio retrospectivo de pacientes con AR y enfermedad pulmonar intersticial (patrón restrictivo en las pruebas de la mecánica pulmonar y evidencia de enfermedad pulmonar intersticial en la tomografía de alta resolución (TCAR)). Los pacientes fueron evaluados para excluir otras causas de enfermedad pulmonar. La actividad de la AR fue medida con el índice clínico de actividad de la enfermedad (CDAI). La inflamación y la fibrosis pulmonar fueron evaluadas con el método de Kazerooni. Se realizó una correlación entre las puntuaciones de vidrio deslustrado del método de Kazerooni con la puntuación más cercano del índice de CDAI. En 9 pacientes se comparó la primera puntuación del vidrio deslustrado con la segunda puntuación después del tratamiento con corticosteroides y fármacos modificadores de la enfermedad (FARME). El coeficiente de correlación de Spearman fue utilizado para evaluar la correlación del índice de CDAI y la puntuación de Kazerooni de vidrio despulido y fibrosis.
ResultadosSe incluyeron 34 pacientes. Se encontró una correlación de rs= 0.3767 (P<0.028) entre las puntuaciones del CDAI y las del vidrio deslustrado. El índice de CDAI y las puntuaciones de fibrosis no estaban asociadas (rs= -0.0747, p<0.6745). En los 9 pacientes con una segunda TCAR, después del tratamiento, se encontró una tendencia a una menor puntuación de la escala de vidrio deslustrado (mediana [IIC]): (2.33 [2,3] vs. 2 [1.33-2.16]), p<0.056, además de una tendencia a una menor puntuación del CDAI (mediana [IIC]): (2.33 [2,3] vs. 2 [1.33-2.16]), p<0.056.
ConclusionesExiste una correlación entre la actividad de la AR y la presencia de vidrio despulido en la TCAR en los pacientes con EPI-AR. Este resultado sugiere una asociación positiva entre la actividad de la AR y el daño pulmonar.
Rheumatoid arthritis (RA) is a systemic inflammatory autoimmune disease capable of producing interstitial lung disease (ILD).1 The presence of ILD confers a poor prognosis in RA patients with a survival median of 2.6 years after ILD diagnosis.2 RA-ILD is perhaps the less understood RA manifestation, there is no consensus about its treatment and to date there is no evidence of a direct relationship between RA disease activity and lung inflammation in RA-ILD.
High resolution computed tomography (HRCT) is the preferred imaging tool for the lung parenchyma evaluation when ILD is suspected. In the case of RA-ILD, several HRCT patterns have been described, such as the usual interstitial pneumonia (UIP) pattern or the non-specific interstitial pneumonia pattern (NSIP).3 HRCT may show images such as reticulation and honeycombing that have a good correlation with fibrosis in histopathological analysis. HRCT also can show images (ground-glass opacity) that correlate with inflammatory injury in lung tissue pathology analysis. Both kinds of images (fibrotic images and ground-glass opacity) can be measured with indexes such as that proposed by Kazerooni et al.4 In the case of RA-ILD, it has been described that deterioration in pulmonary function is associated with increasing reticular pattern and sudden new ground-glass pattern disease.5 Ground glass in RA-ILD may improve with high dose corticosteroids with or without DMARDs.5,6 With this in mind, we hypothesized that ground-glass image in HRCT in RA-ILD may have a positive correlation with RA disease activity. Therefore, the objective of this study is to estimate the association between disease activity of RA and lung inflammation and fibrosis evaluated by HRCT from a group of RA-ILD patients.
Patients and methodsA retrospective study that included patients from a cohort of RA-ILD patients evaluated from February 2006 to December 2012. The patients meet the 1987 ARA criteria for rheumatoid arthritis.7 All patients were referred to our institute, a national medical referral center for respiratory diseases, to evaluate their pulmonary symptoms. ILD was defined by a restrictive pattern in pulmonary function tests (TLC<80% in plethysmography, normal FEV1/FVC and FVC<80% in spirometry), a low diffusing capacity for carbon monoxide (DLCO) and evidence of ILD in HRCT. Patients went under evaluation protocol in the interstitial lung disease unit in order to exclude other causes of disease such as infection, aspiration, drug toxicity or tumors. All patients are evaluated by pulmonologists with experience in ILD, a radiologist and a rheumatologist with experience in ILD-RA. Diagnosis of ILD is reached by consensus of pulmonologists, pathologist, radiologist and rheumatologist as recommended by the American Thoracic Society/European Respiratory Society International Multidisciplinary Consensus Classification of the Idiopathic Interstitial Pneumonias.8 Once RA-ILD was defined as the cause of pulmonary symptoms and other causes of pulmonary abnormalities were excluded, the treatment was decided in consensus of the attending pulmonologist and rheumatologist.
RA disease activity is measured with the clinical disease activity index (CDAI).9 We estimate the correlation with disease activity and ground-glass opacity and fibrosis with the nearest CDAI score to basal HRCT, the CDAI score should have been taken ≤3 months apart from basal HRCT. The principal features of therapeutic decision were RA activity measured by CDAI and changes in pulmonary function tests and/or DLCO measured every 3–6 months. After the complete evaluation of the patients in the interstitial lung disease unit, patients were treated with DMARDs in monotherapy or combination (methotrexate, leflunomide, sulphasalazine or azathioprine) plus corticosteroids. One patient was treated with prednisone, methotrexate, leflunomide and rituximab. Patients were followed in medical appointments by a pulmonologist and a rheumatologist at least three times a year each. The Institutional ethics committee of our institute reviewed and approved the study.
High resolution computed tomography scanningHRCT was performed with 1.0 or 1.5mm thick axial section taken at 1cm intervals throughout the entire thorax, and were reconstructed using a high-spatial frequency algorithm. Between 20 and 25 CT scan images were acquired in each patient. HRCT was evaluated by one expert reader blinded to clinical data. HRCT patterns were determined and classified according to American Thoracic Society/European Respiratory Society International Multidisciplinary Consensus Classification of the Idiopathic Interstitial Pneumonias. Inflammation and fibrosis scores were determined by the method proposed by Kazerooni et al.4 Briefly, the reader observes three images taken at the level of the aortic arch, the carina and 1cm above the diaphragm and then, gives a score on a scale of 0–5 for both alveolar and interstitial abnormality according to the scheme proposed by Kazerooni et al.4 After that, an average of the images is calculated. Our reader has a good concordance, with an intraclass correlation coefficient of 0.90 (95% confidence interval [CI], 0.84–0.94; P<0.0001) in the evaluation of the Kazerooni index.10 Kazerooni ground-glass score and fibrosis score were correlated with that nearest CDAI score to HRCT date scan.
In 9 patients we had access to a second HRCT scan (one to two years after the first one). Basal ground-glass and CDAI scores were compared with follow-up ground-glass and CDAI scores after treatment with corticosteroids and disease modifying anti rheumatic drugs (DMARDs).
Statistical analysisSpearman's rank correlation coefficient was used to evaluate association between CDAI score and the Kazerooni ground-glass and fibrosis scores. Wilcoxon matched-pairs signed-ranks test was used to compare equality of distribution of ground-glass score after treatment. Alpha was set at 5%, two tailed. All analysis was done with Stata statistical package (version10.1, Stata Corp; College station, TX).
ResultsIn the period from February 2006 to December 2012, sixty-nine RA-ILD patients were evaluated in our institution; of these, thirty-four patients had a CDAI index measured within three months apart from the HRCT scan (median (IQR) time difference between HRCT scan to CDAI score was 7 days (4–15 days)). The 34 patients included in this study were not different in age, sex or any other feature with respect to the rest of the RA-ILD patients.
Of the 34 patients included, 88%were female and had a mean age of 60.5±10.5 years old. 87% were rheumatoid factor positive and 71% were anti-cyclic citrullinated peptic antibodies positive. 22% of patients had smoking history and 45% had erosive disease. 57% of the patients had secondary Sjögren syndrome. Patients had a CDAI index score of (median (IQR)): 15.5 (7–29).
Patients had a median (IQR) of RA symptoms duration of 12 (3 –60) months. At baseline evaluation, 52% (17/34) of the patients had no history of methotrexate treatment and 72% (24/34) had not received leflunomide either. The majority of patients (92%) developed pulmonary symptoms before initiating DMARDs. Patients follow-up had a median (IQR) of 32 months (14–45 months), with regular consultations at the ILD clinic, at least three consultation every year. During follow-up, 3 patients died, two of community acquired pneumonia and one of respiratory failure secondary to progression of interstitial lung disease. Death of patients occurred after 36, 42 and 45 months of follow-up, respectively. Of the 3 patients who died, 2 did not receive methotrexate at any time, the other patient withdrew this drug and had progressive ILD. In Table 1, a description of the patients included in this study is done.
Characteristics of the patients enrolled in this study.
| Patients (n: 34) | |
|---|---|
| Age | 60.5±10.5 years old |
| Female sex | 30 (88%) |
| Rheumatoid factor positivity | 27/31 (87%) |
| Anti CCPb positivity | 16/22 (72%) |
| Forced vital capacity (% of predicted) | 69.64±26.05 |
| DLCOc (% of predicted) | 57.46±31.47 |
| CDAIa index score, median (IQR) min, max, | 15.5 (7–29) 0–62 |
| Kazerooni ground-glass score, median (IQR) min, max. | 3 (2–3) 1.6–4.3 |
| Kazerooni fibrosis score, median (IQR) min, max. | 1 (0–1.6) 0–2.5 |
| Patients follow-up after baseline evaluation, median (IQR) min, max. (months of follow-up) | 32 (14 –45)1– 74 |
IQR: interquartile range.
Likely nonspecific interstitial pneumonia was the most prevalent pattern on HRCT scans (29%). UIP pattern was observed in 13% of the patients. Nevertheless, there was considerable overlap between tomographic patterns: 42% of the patients had two ILD tomographic patterns. 20% of the patients had also small airway disease defined by the presence of mosaic attenuation and air trapping images.
Spearman's rank correlation coefficient (rs) for ground-glass and CDAI scores was 0.3767 (P<0.0281) (Fig. 1). Fibrosis score and CDAI score were not associated (rs=−0.0747, P<0.6745).
In the nine patients with a second HRCT scan, after a period treatment with corticosteroids and DMARDs of one to two years, a tendency of lowering in ground-glass score was observed (median [IQR]): (2.33 [2,3] vs. 2 [1.33–2.16]), P<0.056, along with lowering in CDAI score (27 [8–43] vs. 9 [5–12]), P<0.063 (Fig. 2).
Representative images of HRCT scan after and before treatment with prednisone and DMARDs. (A) Basal HRCT images, showing bilateral ground-glass images, centroliobular nodules and lobular areas of decreased attenuation. (B) There is a general improvement of the ground glass and no images of centroliobular nodules and lobular areas of decreased attenuation. The patient was treated with prednisone, methotrexate and sulphasalazine. There is a difference of 16 months between basal HRCT (A) and follow-up HRCT (B).
The results of the study show a correlation between RA disease activity and lung inflammation evaluated by HRCT in RA-ILD patients. To our knowledge, this is the first time this association is described. On the other hand, no association between RA activity and the fibrosis score was found. The results of our study are in accordance with the hypothesis that lung inflammation seen in RA-ILD patients evaluated by HRCT is secondary to RA activity. A second observation of this study is that the Kazerooni ground-glass score and the CDAI score, although not statistically significant, had lower scores after medical treatment with DMARDs and prednisone.
Some may argue that the rs score reported in this study is moderated. To give a correct interpretation of the correlation described, first, we have to consider that HRCT is an indirect estimator of inflammation in interstitial lung disease, and it has only a moderate correlation with inflammation found in the pathological lung tissue analysis. So, a high correlation may be very hard to find with a moderate estimator of inflammation such as ground-glass pattern in HRCT. Second, improvement is seen in the small sample of 9 patients with a second HRCT, and this improvement is also seen in RA disease activity measured with the CDAI index. This result can be interpreted as both the ground-glass score and the CDAI score showed improvement after medical treatment. In this case, the difference was not statistically significant, but, a tendency toward significance was found in a small sample of 9 patients. We believe that all these results are consistent with the original hypothesis of our work: that ground-glass image in HRCT in RA-ILD may have a positive correlation with RA disease activity.
No association between RA disease activity and the fibrosis score was found. Nevertheless we have to admit that, in order to describe that RA disease activity is associated to fibrosis in RA-ILD, a different study design should be done. Only a longitudinal study with repeated measures of disease activity in RA-IL patients, and subsequent measures of the fibrosis score in HRCT scans may answer if there is an association between RA disease activity and fibrosis in RA-ILD.
The most prevalent HRCT pattern seen in this small sample of patients was the NSIP likely pattern. Also, 42% of the patients had two recognizable patterns in the HRCT scan. Kim et al. 11 described that an indeterminate UIP/NSIP pattern was seen in 52% of a RA-ILD patients’ cohort. In this work we do not intended to describe the prevalence of the HRCT patterns in our RA-ILD cohort. We only evaluated patients with a CDAI score that was near to the HRCT scan in order to evaluate for an association between RA disease activity and ground-glass image in HRCT scan.
Another point to consider is the possibility of pulmonary drug related problems. We believe that no patient included in this study had such problems. Patients are evaluated and diagnosed by consensus of clinicians (pulmonologists, radiologists and a rheumatologist) with experience in ILD as has been recommended.8 Pulmonary drug toxicity is always considered and excluded. The most important fact is that 92% of the patients in this study developed pulmonary symptoms before initiating methotrexate or leflunomide. Recently the association between ILD and drug toxicity has been questioned.12 A recently published review summarizes all the data questioning this association.13
Our study has limitations owing to its retrospective nature. The lapse in time between the CDAI score and the HRCT is the first and more important limitation. Another limitation is the Kazerooni score, it was not designed for the evaluation of RA-ILD, it was designed for the evaluation of idiopathic pulmonary fibrosis. We choose this method for the evaluation of RA-ILD because of the high experience of our reader, and because it has a different score for fibrosis and ground glass, the results obtained in the study are according to our original hypothesis. So, in the absence of a validated score for the evaluation of RA-ILD fibrosis and ground glass in HRCT images, we think that the Kazerooni score can be used for this purpose. Another limitation is that owing to the small sample size, no multivariable analysis or subgroup analysis could be done. Although our study has the after mentioned limitations, we believe this information is useful in the understanding of a severe RA manifestation, and it may be the basis for prospective studies evaluating the association between disease activity and inflammation in ILD-RA.
In conclusion, the results presented in this study show a correlation between RA disease activity and ground-glass score in HRCT scan. This observation is in accordance with the hypothesis that inflammation seen in RA-ILD may be secondary to RA disease activity.
Ethical responsibilitiesProtection of human and animal subjectsThe authors declare that the procedures followed were in accordance with the regulations of the responsible Clinical Research Ethics Committee and in accordance with those of the World Medical Association and the Helsinki Declaration.
Confidentiality of dataThe authors declare that they have followed the protocols of their work center on the publication of patient data and that all the patients included in the study have received sufficient information and have given their informed consent in writing to participate in that study.
Right to privacy and informed consentThe authors have obtained the informed consent of the patients and/or subjects mentioned in the article. The author for correspondence is in possession of this document.
FundingNone.
Conflict of interestWe declare we have no conflicts of interest.
Please cite this article as: Pérez-Dórame R, Mejía M, Mateos-Toledo H, Rojas-Serrano J. Enfermedad intersticial pulmonar asociada a Artritis Reumatoide: La inflamación pulmonar evaluada mediante tomografía computarizada de alta resolución correlaciona con la actividad de la enfermedad de Artritis Reumatoide. Reumatol Clin. 2013;11:12–16.